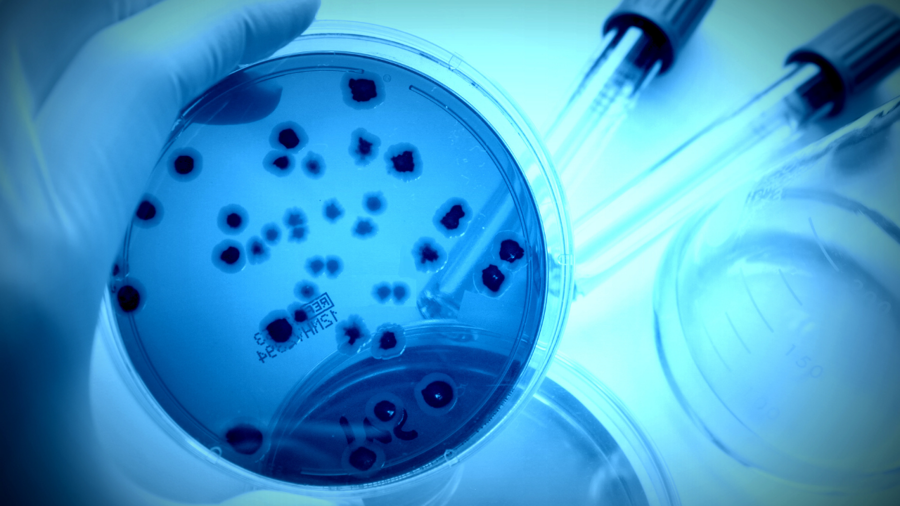
Mikrobiyoloji Cihazları

Hakkımızda
GENBİYO TEKNOLOJİLERİ LABORATUVAR ÜRÜNLERİ 2018 yılında kurulmuş olup kalite kontrol ve araştırma laboratuvarlarına yönelik satış, servis ve yedek parça temini; validasyon, aplikasyon ve eğitim hizmetleri sunmaktadır.
Bölgemizde, dokuz ilimizde faaliyet gösteren firmamız ilaç, gıda, kimya, çevre, madencilik ve sağlık gibi birçok farklı alanda yenilikçi analitik çözümler sunuyoruz.
Başlıca ürünlerimiz:
• Analitik Cihazlar
• Disolüsyon Test Cihazları
• Mikrobiyolojik Test Sistemleri
• Moleküler Mikrobiyolojik Testler
• Temel ...
Ürün Grupları
GENBİYO TEKNOLOJİLERİ
KAHVEYE BEKLİYORUZ
Projelerimiz hakkında daha detaylı bilgi sahibi olmanız adına, sizi ofisimizde misafir etmekten mutluluk duyarız.
Öne Çıkan Ürünlerimiz
Blog / Duyuru
07
Ekim
Genbiyo Teknolojileri Web Sitesi Yenilendi !
Merhaba, sizlere daha kaliteli hizmet verebilmek için web sitemizi yeniledik. Web sitemizde artık ürünlere, ...